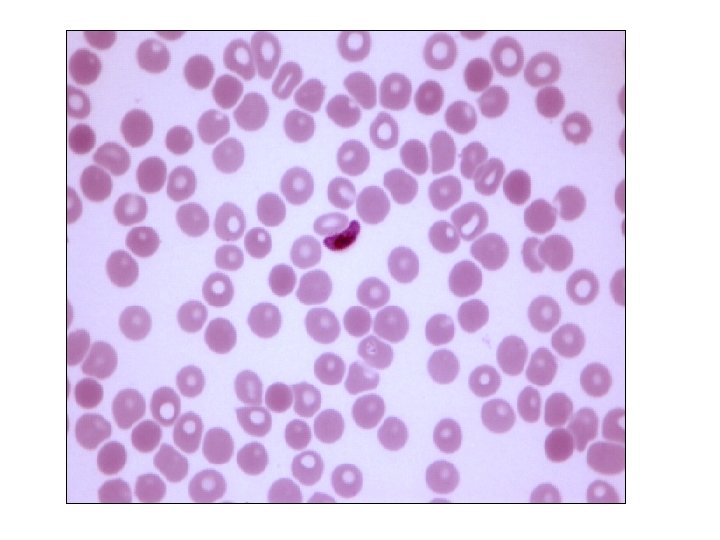

Rhino DNA Indexing System Rh ODIS a DNAbased


Rhino DNA Indexing System (Rh. ODIS) • a DNA-based forensic tool • The Rh. ODIS, used to investigate and prosecute suspects in cases of rhino poaching. • The tool involves the collection of each individual rhino’s unique DNA profile into a database which can be referenced when presenting legal evidence in cases of rhino poaching.

Advantage • The Rh. ODIS would help provide concrete evidence before the trial court, as required for conviction in poaching cases

Rhino Poaching

• poachers killed and dehorned 41 rhinos in Assam in 2013. • poaching had been posing a major threat to rhino conservation efforts. It was the market in China and Vietnam, which use the rhino horn for various purposes, including medicinal, that the poachers sought to tap

Ayurgenomics • Coined in 2001 • Derives from practice in Ayurveda to define an individual’s predisposition and habitus • Gene-mapping said to help predict disease susceptibility and behavioural pattern • Critics claim little science to back it at the moment • Separate unit within the Institute of Genomics and Integrative Biology, New Delhi • Collaboration on with several institutions

Biofuel • A biofuel is a fuel that contains energy from geologically recent carbon fixation. • These fuels are produced from living organisms. Examples of this carbon fixation occur in plants and microalgae. • These fuels are made by a biomass conversion (biomass refers to recently living organisms, most often referring to plants or plant-derived materials).






• First-generation biofuels • 'First-generation' or conventional biofuels are made from sugar, starch, or vegetable oil.

• Second-generation (advanced) biofuel • Second generation biofuels, also known as advanced biofuels, are fuels that can be manufactured from various types of biomass. ( Biomass is a wide-ranging term meaning any source of organic carbon that is renewed rapidly as part of the carbon cycle. Biomass is derived from plant materials but can also include animal materials. ) • First generation biofuels are made from the sugars and vegetable oils found in arable crops, which can be easily extracted using conventional technology. In comparison, second generation biofuels are made from lignocellulosic biomass or woody crops, agricultural residues or waste, which makes it harder to extract the required fuel.


Third Generation • The term third generation biofuel has only recently enter the mainstream it refers to biofuel derived from algae. Previously, algae were lumped in with second generation biofuels. However, when it became apparent that algae are capable of much higher yields with lower resource inputs than other feedstock, many suggested that they be moved to their own category.



• This biomass can be converted to convenient energy containing substances in three different ways: thermal conversion, chemical conversion, and biochemical conversion

Ethanol • Ethanol fuel is the most common biofuel worldwide, particularly in Brazil. • Alcohol fuels are produced by fermentation of sugars derived fromwheat, corn, sugar beets, sugar cane, molasses and any sugar or starch from which alcoholic beverages such as whiskey, can be made (such as potato and fruit waste, etc. ). • The ethanol production methods used are enzyme digestion (to release sugars from stored starches), fermentation of the sugars, distillation and drying. The distillation process requires significant energy input for heat (often unsustainable natural gas fossil fuel, but cellulosic biomass such as bagasse, the waste left after sugar cane is pressed to extract its juice, can also be used more sustainably).

• Ethanol can be used in petrol engines as a replacement for gasoline; it can be mixed with gasoline to any percentage. Most existing car petrol engines can run on blends of up to 15% bioethanol with petroleum/gasoline. • Ethanol has a smaller energy density than that of gasoline; this means it takes more fuel (volume and mass) to produce the same amount of work.

• Biodiesel is the most common biofuel in Europe. It is produced from oils or fats using transesterification and is a liquid similar in composition to fossil/mineral diesel. • Chemically, it consists mostly of fatty acid methyl (or ethyl) esters (FAMEs). • Feedstocks for biodiesel include animal fats, vegetable oils, soy, rapeseed, jatropha, mahua, mustard, flax, sunflower, palm oil, hemp, field pennycress, Pongamia pinnata andalgae. Pure biodiesel (B 100) is the lowestemission diesel fuel. Although liquefied petroleum gas and hydrogen have cleaner combustion, they are used to fuel much less efficient petrol engines and are not as widely available.

BIOGAS • Biogas is methane produced by the process of anaerobic digestion of organic material by anaerobes. It can be produced either frombiodegradable waste materials or by the use of energy crops fed into anaerobic digesters to supplement gas yields. The solid byproduct, digestate, can be used as a biofuel or a fertilizer.

SYNGAS • Syngas, a mixture of carbon monoxide, hydrogen and other hydrocarbons, is produced by partial combustion of biomass, that is, combustion with an amount of oxygen that is not sufficient to convert the biomass completely to carbon dioxide and water. Before partial combustion, the biomass is dried, and sometimes pyrolysed. The resulting gas mixture, syngas, is more efficient than direct combustion of the original biofuel; more of the energy contained in the fuel is extracted.

World wide Efforts • There are international organizations such as IEA Bioenergy, established in 1978 by the OECD International Energy Agency (IEA), with the aim of improving cooperation and information exchange between countries that have national programs in bioenergy research, development and deployment. • The UN International Biofuels Forum is formed by. Brazil, China, India, Pakistan, South Africa, the United States and the European Commission

Bio fuel in India • The demand for transportation fuels is growing rapidly in India. In order to cut down its dependence on imports, the country has been focusing on environmentally friendly alternatives like biofuels. • It is in this context that the Go. I announced its 'National Biofuel Policy' on 12 September 2008. The government aims to meet 20% of India's diesel demand with fuel derived from plants.

• At present, ethanol is the most widely produced biofuel in India , it is being produced from sugarcane waste which is abundantly available in the country.

• Recently, biologically produced butanol has emerged as an alternative biofuel. Butanol has proved to be a better biofuel than the widely acclaimed ethanol, because it is less corrosive and it can easily blend with gasoline. • Moreover, butanol can be produced from lignocellulosic biomass of sugarcane waste because of which, manufacturers feel that the existing ethanol distilleries can be upgraded for the production of butanol.

• The January 2013 notification by Go. I said that by 2017, every litre of petrol should be blended with 20% of ethanol. As a result, some companies are planning investments for capacity expansion and new plants to cater to the anticipated requirement, while others are looking at focusing on research and development to tap alternative methods for ethanol production. However, the research is still at a very nascent stage, especially when we talk about butanol production in India

Jatropha plant seeds which are very rich in oil (40%), have a very high potential in Indian context


Common Diseases


Tetanus • A disease of the nervous system caused by a toxin produced by the bacterium Clostridium tetani. This bacterium produces spores, which are resistant cells able to survive in the soil for many years. • Symptoms include painful muscle spasms, initially of the muscles of the neck and jaw (lockjaw), and later of the muscles of the trunk. Tetanus is a very serious disease and is frequently fatal, particularly in infants and the elderly. It has become relatively common in intravenous drug users.

Tetanus

• Treatment requires the administration of antitoxin and antibiotics. Often prolonged treatment in intensive care unit of a hospital is necessary. • Protection against tetanus is provided by tetanus toxoid vaccine.

Caused by Bordetella pertussis (Bacteria )


• Treatment Antibiotic therapy


• Caused by : - corynebacterium diphtheriae


Hepatitis B • Causative agent - Hepatitis B virus (HBV) • infects the liver and can cause liver inflammation called "hepatitis"

Spread - mother to her child during birth -unprotected sexual contact -sharing needles among injection drug users, -re-use of contaminated needles and syringes - Unsafe blood transfusion

Haemophilus influenza type B

• One of the important cause on neonatal meningitis.

Measles

Caused by Measle Virus

• Usually children become susceptible to Measles around the age of nine months, probably because they are protected up to this period by the antibodies (proteins that protect against a disease) against Measles, received from their mothers.


India’s fight against measles • After polio…. it’s time to fight measles. . • An estimated 56, 000 children died from measles in 2011 alone, which translates to about 156 deaths each day.

• From 2010 to 2012, India conducted its first national campaign for measles. Over 119 million children between the ages of 9 months and 10 years were inoculated. And in 2013, the government of India initiated special immunization weeks, much like the National Immunization Days for polio vaccinations.

• Fortunately, the measles vaccine is one of the most effective, and it provides lifelong protection from the disease

Challenges • Measles is not like polio, because the vaccine is an injectable. Anyone in just a half-hour training can administer polio vaccine …But for measles vaccinations, we need trained manpower and these health workers within the government are limited. .

Measle vaccine is an attenuated (weakened) live virus vaccine. This means that after injection, the viruses grows and causes a harmless infection in the vaccinated person with very few, if any, symptoms. The person's immune system fights the infection caused by these weakened viruses and immunity develops which lasts throughout that person’s life….

Mumps

• Caused by Paramyxo virus


• Mumps is spread by droplets of saliva or mucus from the mouth, nose, or throat of an infected person, usually when the person coughs, sneezes, or talks. Items used by an infected person, such as soft drink cans or eating utensils, can also be contaminated with the virus, which may spread to others if those items are shared.

Rubella


NATIONAL VECTOR BORNE DISEASE CONTROL PROGRAMME

Introduction q Launched in year 2003 -04 q Major vector borne diseases • Malaria • Filaria • Kala-azar • Japanese Encephalitis • Dengue / Dengue Hemorrhagic fevers • Chikungunya


• Causative agent : Plsmodium (Plasmodium vivax Plasmodium falciparum plasmodium ovale plasmodium malariae )

• Vector (Carrier ) – Female Anopheles mosqitoe



Strategies: Malaria q Early case detection and prompt treatment (EDPT) v Clinically suspected malaria cases are confirmed on microscopy or rapid diagnostic kits(RDK) v Drug Distribution Center (DDC) and Fever Treatment Depots(FTD) have been established in rural areas v In inaccessible areas, Health agencies and volunteers running FTD’s are provided with RDK’s


DENGUE • Causative organism : - Dengue virus






Chickungunya symptoms • • Debilitating joint pain, swelling of joints, stiffness of joints, muscular pain headache, Weakness, nausea, vomiting rash and fever


Strategies: Dengue & Chikungunya Early case detection and prompt treatment • Identified Apex Referral Laboratories for advanced diagnosis and regular surveillance. • Identified sentinel surveillance hospitals for proactive surveillance. • NIV Pune entrusted to supply ELISA test kits to these institutes


Japanese Encephalitis (JE)

• Causative organism : JE virus • Carrier/Vector : Culex Tritaeniorhyncus



• Japanese encephalitis, a mosquito-borne viral infection, is the most common cause of viral encephalitis in eastern Uttar Pradesh (U. P. ) • Overall affecting 171 districts and claiming hundreds of lives every year. • Death is higher among children and thousands of them in this area have been rendered disabled by it.

Govt. Strategies: Japanese Encephalitis Early case detection and prompt treatment. Clinical surveillance in endemic areas JE Vaccination Program. In endemic district

Current @ JE India launches vaccine to prevent Japanese encephalitis (Oct 2013) The Vero cell-derived purified inactivated JE vaccine–JENVAC, is the first vaccine to be manufactured in the public-private partnership mode between the Indian Council of Medical Research and Bharat Biotech.

• The most significant benefit JENVAC brings over live attenuated vaccines (those that reduce the harmful effects of pathogens but keep them viable) is that it can be administered during an epidemic as it is a highly purified and inactivated vaccine.

• The results proved that JENVAC can be administered as a single dose during epidemics for mass vaccination campaigns and also as a two-dose schedule during routine immunisation as part of the National immunisation programme in endemic regions.

• • Also called leishmaniasin Caused by Leishmania donovani (Protozoa ) Carrier/Vector – Sandfly (Phlebotomus ) Human to human transmission

Organs affected



Strategies: Kala-azar Enhanced case detection and Complete treatment • Every case of fever of more than 15 days duration in endemic areas , not responding to anti-viral t/t or antibiotics with spleenomegaly is screened. • Rapid diagnostic kit RK 39 has replaced Aldehyde Test for diagnosis of Kala-azar. • Introduction of oral drug Miltefosine as the first line drug since 2008. • Directly observed treatment in RDT endemic areas

Filariasis/ Elephentiasis

- vector : -Black fly -culex mosqitoe

Causative agent – Filaria (Nematod) (round worm )


Strategies: Filaria q Mass Drug Administrationq. Single dose mass t/t with DEC every year q 85% DEC coverage for 5 years.

Filaria Control Strategies… q Morbidity management of cases/ Rehabilitaion

Preventive strategies

INTEGRATED VECTOR MANAGEMENT • Source reduction, filling, streamlining water bodies • Biological Control-Gambusia Fishes & Biolarvicides (Bacillus sphaericus) • Impregnated bed nets • DDT spraying in and around 30 households from a diagnosed case of malaria • IEC campaigns GAMBUSIA FISHES Abandoned Cement Tank

INTEGRATION UNDER NRHM At Village Level Ø Monthly meetings of Village Health & Sanitation Committee serve as a platform for health education and counseling of community. Involvement of ASHA asØ surveillance worker to inform any increase in fever cases including Dengue/ Chikungunya and J. E. Ø FTD for early detection of suspected malaria cases and treatment Ø linkage between ANC services and prevention & treatment of malaria Ø counselor for Filaria cases to practice home based management. Ø organizer, motivator and trainer in village level meetings/training workshops.


National Programme for Prevention and Control of Cancer, Diabetes, Cardiovascular diseases and Stroke (NPCDCS) approved

• The NPCDCS aims at integration of NCD ( noncommunicable diseases )interventions in the NRHM framework for optimization of scarce resources and provision of seamless services to the end customer / patients as also for ensuring long term sustainability of interventions. • Thus, the institutionalization of NPCDCS at district level within the District Health Society, sharing administrative and financial structure of NRHM becomes a crucial programme strategy for NPCDCS.

• The NCD cell at various levels will ensure implementation and supervision of the programme activities related to health promotion, early diagnosis, treatment and referral, and further facilitates partnership with laboratories for early diagnosis in the private sector. • Simultaneously, it will attempt to create a wider knowledge base in the community for effective prevention, detection, referrals and treatment strategies through convergence with the ongoing interventions of National Rural Health Mission (NRHM), National Tobacco Control Programme (NTCP), and National Programme for Health Care of Elderly (NPHCE) etc and build a strong monitoring and evaluation system through the public health

Non communicable disease (NCD)



Cause of cancer

Carcinogens

• A carcinogen is any substance, radionuclide, or radiation that is an agent directly involved in causing cancer. This may be due to the ability to damage the genome or to the disruption of cellular metabolic processes.

• Carcinogens can be grouped into one of three categories: • (1) physical carcinogens, • (2) biologic carcinogens, and • (3) chemical carcinogens.
![• “physical carcinogen” encompasses multiple types of radiation (e. g. , ultraviolet [UV] • “physical carcinogen” encompasses multiple types of radiation (e. g. , ultraviolet [UV]](http://slidetodoc.com/presentation_image_h2/bbf72ea5d42d93f954b3fd6b22afbe9e/image-116.jpg)
• “physical carcinogen” encompasses multiple types of radiation (e. g. , ultraviolet [UV] and ionizing radiation).

• Biologic carcinogens refer to viral and bacterial infections that have been associated with cancer development (e. g. , human papilloma virus [HPV] and hepatitis B virus [HBV])

• Most carcinogens can be categorized as chemical carcinogens. • Example heavy metals, organic combustion products , hormones, and fibers (e. g. , asbestos), etc.

Oncogene • An oncogene is a sequence of deoxyribonucleic acid (DNA) that has been altered or mutated from its original form, the proto-oncogene. • carries the ability to induce cancer

Proto oncogene • The proto-oncogene is involved in promoting the differentiation and proliferation of normal cells. A variety of proto-oncogenes are involved in different crucial steps of cell growth, and a change in the proto-oncogene’s sequence or in the amount of protein it produces can interfere with its normal role in cellular regulation.


Tumour supressor gene • A tumor suppressor gene, or antioncogene, is a gene that protects a cell from cancer • When this gene mutates to cause a loss or reduction in its function, the cell can progress to cancer • Example : - BRCA 1 and BRCA 2. (Harmful mutations in these tumor suppressor genes produce a hereditary breast-ovarian cancer syndrome in affected families. )

Tumour Markers/Cancer Biomarker • A tumor marker is a substance found in the blood, urine, or body tissues that can be elevated in cancer, among other tissue types. • There are many different tumor markers, each indicative of a particular disease process, • They are used in oncology to help detect the presence of cancer. An elevated level of a tumor marker can indicate cancer; however, there can also be other causes of the elevation.


Diabetes


Alpha cells – release glucagon (increase glucose in blood) Beta cells – release insulin (decrease glucose in blood)

Type – 1 Diabetes • Destruction of Beta cells – impaired production of insulin


Hyperglycemia • Hyperglycemia, or high blood sugar is a condition in which an excessive amount of glucose circulates in the blood plasma.

Hypoglycemia • involves an abnormally diminished content of glucose in the blood.

Blood Glucose test • A blood glucose test measures the amount of a type of sugar, called glucose, in your blood.

• Fasting blood sugar (FBS) measures blood glucose after you have not eaten for at least 8 hours. It is often the first test done to check for prediabetes anddiabetes.

• 2 -hour postprandial blood sugar measures blood glucose exactly 2 hours after you start eating a meal. This is not a test used to diagnose diabetes. •

• Random blood sugar (RBS) measures blood glucose regardless of when you last ate. Several random measurements may be taken throughout the day. Random testing is useful because glucose levels in healthy people do not vary widely throughout the day. Blood glucose levels that vary widely may means a problem. This test is also called a casual blood glucose test.

• Oral glucose tolerance test is used to diagnose prediabetes and diabetes. An oral glucose tolerance test is a series of blood glucose measurements taken after you drink a sweet liquid that contains glucose. This test is commonly used to diagnose diabetes that occurs during pregnancy (gestational diabetes). This test is not commonly used to diagnose diabetes in a person who is not pregnant.

• Glycohemoglobin A 1 c measures how much sugar (glucose) is stuck to red blood cells. This test can be used to diagnose diabetes. It also shows how well your diabetes has been controlled in the last 2 to 3 months and whether your diabetes medicine needs to be changed. The result of your A 1 c test can be used to estimate your average blood sugar level. This is called your estimated average glucose, or e. AG.

Cardio vascular disease

Atherosclerosis

stroke


- Slides: 142